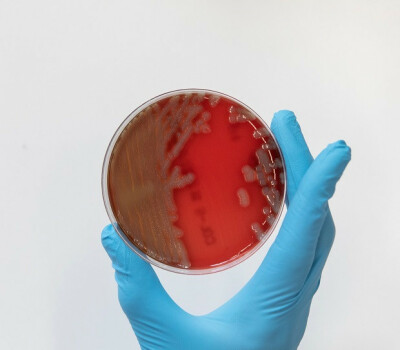

Ebola
ITM has been tackling Ebola since its first outbreak.
The Ebola virus is a rare and often fatal disease that causes a hemorrhagic fever. This filamentous virus (or filovirus) is a classic example of an infectious disease that was accidentally transmitted from animal to man and poorly adapted to humans (also called a "zoonotic" disease).
It was co-discovered in 1976 by ITM researchers Guido van der Groen and Peter Piot at the time of its first known outbreak in Yambuku (Zaire, Democratic Republic of the Congo). ITM made a name for itself during subsequent epidemics as well:
Dr Bob Colebunders helped combat the Ebola outbreak of 1995 in Kikwit (Zaire, DRC).
Prof Johan Van Griensven coordinated a large-scale European research project on the treatment of Ebola, during the unprecedented epidemic in West Africa (2014-2015).
Prof Kevin Ariën (at the time Head of the Virology Unit) ensured that the disease could be diagnosed in Antwerp.
ITM physician Erika Vlieghe acted as Belgium’s national Ebola coordinator.
Units
Ebola website
Stay informed on the latest disease outbreaks and measures of governmental authorities in the world. The Ebola website is a joint project of ITM and the different governments and communities of Belgium.

Uncovering the Ebolavirus: The Journey of ITM Researchers in Discovery and Research
ITM researchers Guido van der Groen and Peter Piot co-discovered the Ebola virus, which was first studied in Zaire in 1976.Projects
EBO-BOOST
We aim to address the ongoing threat of the Ebola Virus Disease by investigating optimal timing and safety of booster vaccinations for rapid deployment during outbreaks, and strengthening local epidemic preparedness.